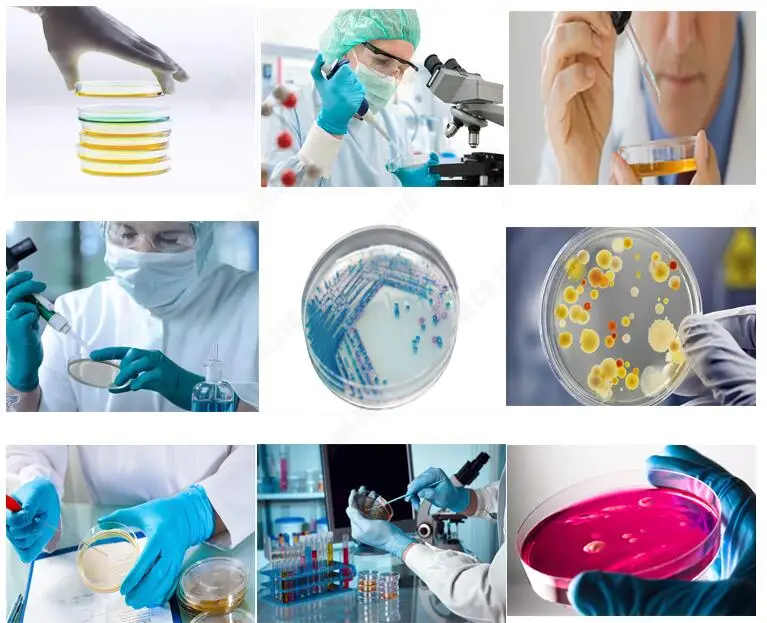

Одноразовая чаша Петри 90 мм стерильная
- Категории: Чашка Петри >>>
- Поставщик: Qingdao,Ama,Co.,Ltd.,[Shandong,China]Qingdao
Поделиться:
Описание и отзывы
Характеристики
Одноразовые чашки Петри 90 мм стерильные пластиковые чашки Петри
Преимущества товара:
1) чаша Петри гладкая, и светопроницаемость может помочь наблюдать за ростом бактерий и количеством бактерий.
2) рельефная линия на крышке усилит воздухопроницаемость изделия.
3)EO стерилизованный, Стерилизация электронного луча и гамма-лучей.
4) чаша Петри имеет умеренно Тугую крышку.
Храктеристика устройства:
Модель изделия | Материал | Кол-во/Сумка | Кол-во/ctn |
Тарелка Петри 35x15 мм |
PS | 20 | 2600 |
Тарелка Петри 60x15 мм | 26 | 1040 | |
Блюдо Петри 65x15 мм (Сетка количество) |
20 |
1000 | |
Тарелка Петри 70x15 мм | 20 | 700 | |
Чаша Петри 75x15 мм (Два динамика) |
10 |
360 | |
90x15 мм чаша Петри | 10 | 500 | |
90x15 мм чаша Петри (Две решетки) |
10 |
500 | |
90x15 мм чаша Петри (Три) |
10 |
500 | |
90x20 мм чаша Петри | 15 | 375 | |
Чаша Петри 150x15 мм | 10 | 180 |
Применение продукта:
|  | |
| Пробирка | Центрифужная пробирка | Стаканчик для мочи |
 |  |  |
| Pastur пипетка | Вакуумная трубка для забора крови | Пластинка клеточной культуры |


В1: Как насчет качества?
Продукты одобрены CE & ISO. Мы имеем более чем 20-летний опыт работы в производство и продажа машин по переработке шин в лабораторное оборудование, мы завоевали хорошую репутацию на рынке.
В2: какие Способы оплаты доступны?
Банковский перевод, аккредитив, PayPal, Western Union и MoneyGram.
В3: Можете ли вы производить в соответствии с дизайном заказчика?
Да, мы являемся профессиональным производителем; OEM и ODM приветствуются.
В4: можем ли мы посетить ваш завод?
Конечно, добро пожаловать на нашу фабрику, если вы приедете в Китай.
В5: Как долго срок действия предложения?
Как правило, наша цена действительна в течение одного месяца с даты расценки. Цена будет скорректирована соответствующим образом по мере колебания цен на сырье на рынке.

























